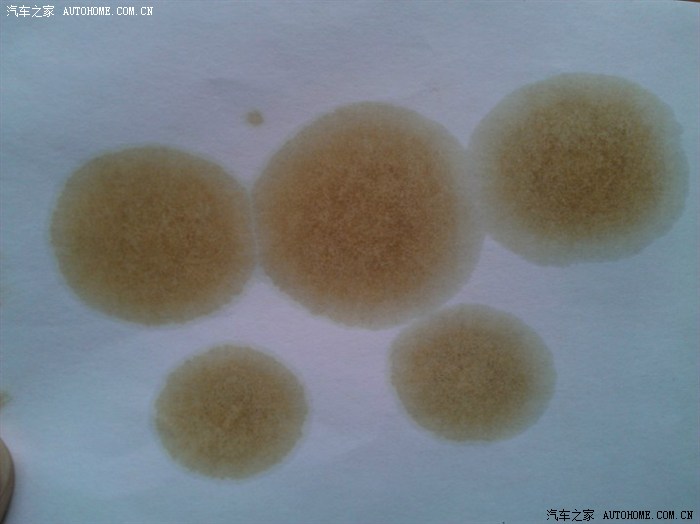
【图】请大家帮忙鉴定一下机油清洁度

领导给保洁员工一个好的评语,使他更努力地工作,更好的完成自己的工作。下面是有保洁工作评语,欢迎参阅。保洁工作评语1. xx同志待人诚恳,作风朴实。该学生严格遵守我单位
随着人类步入信息时代和知识经济时代,市场和人才的竞争日益激烈,企业员工职业发展成功的标准也日益提升并且呈现了时代的特点;下面是有保洁员工工作评语,欢迎参阅。保
58到家保洁员评语专题,我们精心筛选了保洁员评语问答、资讯和视频等海量信息供您参考。 保洁工作是物业管理中一项日常性的管理服务工作,其目的是给业主及住户提供一个
保洁员工工作评语:随着人类步入信息时代和知识经济时代,市场和人才的竞争日益激烈,企业员工职业发展成功的标准也日益提升并且呈现了时代的特点;下面是有保洁员工工作
经济时代,市场和人才的竞争日益激烈,企业员工职业发展成功的标准也日益提升并且呈现了时代的特点;下面是有保洁员工工作评语,欢迎参阅。保
保洁工作评语1、该员工平时工作能将自己的能力充分发挥出来,不仅工作认真、做事效率好,而且上班的纪律也很好,值得各位同事学习 2、该员工平时工作认真,有高速度、高效
下载积分:2500 清洁工个人工作总结评语世上的工作原没有贵贱之分,区别在于你肯不肯用心去做。俗话说的好,行行出状元。保洁工作在很多人眼里虽不值得一提,而自从我干这
清洁工个人工作总结评语清洁工个人工作总结评语保洁员工作小结总结201X年保洁工作年终个人总结世上的工作原没有贵贱之分,区别在于你肯不肯用心去做。
如何写好员工的评语呢?下面是有保洁员优秀员工评语,欢迎参阅。保洁员优秀员工评语 1.工作认真负责,细心,任劳任怨,具有较强的学习能力,接受新
经过实习期间的工作和学习,该生基本上完成了单位交给的各项任务,综合素质得到较大提高,达到了实习的目的。保洁工作评价评语 21.你是一个善良,乐于助人的好女孩.在学习上
【图】请大家帮忙鉴定一下机油清洁度
700x524 - 46KB - JPEG

原创教程:银饰的鉴定与保养知识
600x399 - 36KB - JPEG

小常识:玉石鉴定工具 及 一些矿物的清洗方法
490x365 - 10KB - JPEG

怎么鉴定白金戒指 白金戒指的清洗方法_婚戒首
500x323 - 37KB - JPEG

爱e家家电清洗客户们的评语-汕头澄海区保洁清洗
240x270 - 10KB - JPEG

清洁工清理厕所时发现两块木头,找专人鉴定后
562x750 - 45KB - JPEG

保洁员工工作评语
480x291 - 16KB - JPEG

清洁垃圾场捡到奇怪东西,专家鉴定后称这是人
455x357 - 16KB - JPEG

清洁工清理厕所时发现两块木头,找专人鉴定后
580x435 - 35KB - JPEG

求鉴定机油定性滤纸测试结果
400x267 - 15KB - JPEG

姐妹们帮忙鉴定一下我的钻戒怎么是这样的呢?
690x924 - 72KB - JPEG
小鹿清洗后的样子_小鹿清洗后的样子鉴定_来
640x480 - 73KB - JPEG

宁波奢侈品回收宁波回收名包
700x632 - 58KB - JPEG

【玉佛手如何清洗,价格如何,哪里可以鉴定】-黄
710x415 - 13KB - JPEG

请求鉴定日本大正三年龙洋真伪以及是否清洗-
640x649 - 82KB - JPEG